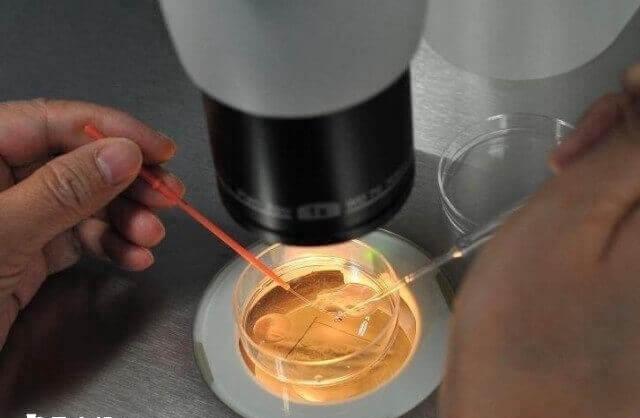
多囊肾可以做三代试管婴儿

染色体结构异常有遗传病多囊肾怎么才能生健康孩子?
发布:2025-07-03 19:00:39
浏览50次
问题描述:
多囊肾是由于染色体结构异常导致的,夫妇一方有染色体结构异常时,临床一般表现为不孕不育、流产、死胎、胎儿先天性畸形等。因此,染色体结构异常导致基因断裂的患者可表现为同时患有单基因遗传病及反复流产。这种情况可以通过第三代试管婴儿的PGT-SR技术来生育健康宝宝!
最佳答案
多囊肾是由于染色体结构异常导致的,夫妇一方有染色体结构异常时,临床一般表现为不孕不育、流产、死胎、胎儿先天性畸形等。因此,染色体结构异常导致基因断裂的患者可表现为同时患有单基因遗传病及反复流产。这种情况可以通过第三代试管婴儿的PGT-SR技术来生育健康宝宝!
染色体结构异常怎么生孩子
染色体结构异常通常通过染色体核型进行检测,但是由于技术局限性常规核型无法确定断点是否发生在关键基因的内部。而对于染色体结构异常导致的遗传病,一般通过下面的检测流程解决生育难题。

染色体结构异常生育方案
染色体结构异常需要先做常规核型、高分辨率染色体分析技术/长片段测序技术、断点验证,然后再考虑是通过第三代试管婴儿还是自然妊娠来生育。
- 1. PGT-SR/PGT-M(选择PGT-SR方案时建议移植非携带型胚胎)、产前诊断、新生儿出生;
- 2. 自然妊娠注(流产风险高)、产前诊断(携带异常染色体的概率为50%)、新生儿出生。
对于明确了致病原因的患者,建议通过三代试管婴儿PGT-SR技术生育健康的宝宝。
好孕交流群 分享心理 链接关系 共同目标
最新问题
- 石河子大学一附院做试管婴儿夫妻挂一个生殖科的号可以吗? 2025-11-04
- 山大生殖医院做第三代试管婴儿要花多少钱? 2025-11-04
- 在济南做试管婴儿,山大生殖和齐鲁医院哪个好? 2025-11-04
- 在济南山大生殖医院做试管婴儿能一次成功吗? 2025-11-04
- 湖南长沙湘雅医院做第三代试管婴儿单周期的费用多少? 2025-11-04
- 中信湘雅医院做试管婴儿,找哪个生殖科医生好? 2025-11-04
热点问题榜
网友关注的问题
排名
主题
阅读量
-
12477 -
212202
-
310773
-
410614
-
510353
-
610308
-
79657
-
89440
-
95849
-
105357
热门资讯
助您好孕多多
医院




